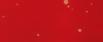

3. Farmlands staff profile
3. From the CEO
5. Partnership to strengthen provincial real estate
6. 5 Minutes with Rob Hewett, Farmlands Chairman
8. Special Feature – Visiting Hours
17. Farmlands announces annual result
18. Tom Cranswick Memorial Award winners
21. Prevention regime takes out Biosecurity Award
23. Just the Boost needed for Kiwi small businesses
24. Shareholder fun in the sun
26. Enhancing irrigation with powerful partnerships
29. Helping your young farmer to become a safe farmer
50. Buying Power Promise
59. Century Farms – 150 Years at Thomson’s Crossing
61. Stylish superhome offers next-level sustainability
62. Property Brokers Real Estate Market Update
Plan365 Nutrition
31. Treating your chooks over the festive season
33. Supplementary feed for alpacas and llamas
37. Feeding for success
Plan365 Animal Management
39. Crawling insects
41. Shearing shed safety
Plan365 Forage and Arable
43. Getting physical with soil
45. Selective control of insect pests via aerial application
47. Beneficial insects worth their weight in gold
Plan365 Horticulture
49. Science smooths harvest peaks and troughs
Plan365 Rural Infrastructure
51. Stock water solutions by design



Gore Store Opening
Farmlands Gore has moved to its brand new location and we would love for you to join us at the official opening! 20-26 Lyne Street, Gore. 24
JANUARY
Farmlands Cup 2020








Frank and Anya Walkington run four farm tours a day at Shamarra Alpaca Farm, trading in hands-on experience, selfies and hugs. The shareholder’s love of the South American beauties has flourished into a popular tourism, product and genetics business. Visitors come from all over to the Akaroa hill-top farm for a unique agri-venture.
Remember to get your tickets to the Crusaders vs Pulse Energy Highlanders at Wanaka A&P Showgrounds

Steve Thompson
Category Manager, Christchurch Wairakei Road
Q: What does your job involve?
A: I look after multiple categories (product groups) such as fencing and animal management. I work closely with suppliers to get the range right in our stores.
Q: Where were you before Farmlands?
A: I used to work for Eurosteel, a supplier for Farmlands! I met quite a few shareholders out and about in that role.
Q: What do you enjoy about your job?


A: Ensuring we are sourcing the most up-to-date and innovative products for our shareholders – at the most competitive rates.
Q: Where are you from originally?
A: New Brighton, Christchurch but I also spent a big part of my childhood in Piha.
Q: What is the most interesting trip you have ever taken?
A: I went snowboarding in Japan not too long ago. It was incredible; they have huge mountains, amazing wildlife and very bizarre food. At one point I ended up eating a sparrow on a stick!
Q: What do you want for Christmas?
A: A pair of Andrew Footwear Antelao Zebru SPX outdoor boots…I hope my wife reads this!
Q: What’s the most exciting thing coming up for shareholders?
A: The Christmas Ham or Hamper promotion of course! A lot of the items in the hamper I use when cooking my own Christmas ham.




Welcome to our final edition of The Farmlander for the year. At the end of October we announced our annual result, which we have described as good but not great. We have been vocal about our aim to be great so while challenging conditions played their part, as a business we continue to work to be more adaptable to the challenges that face our sector.
The decision not to pay a Bonus Rebate was based on prudency. We need to be responsible with the co-operative’s money and in the years to come the efficiencies gained through the Braveheart Programme provide an opportunity to reduce the need for this action. You can read more about our annual result announcement on page 17.
The challenges of this year are offset by the visible progress we have made. It was a year of milestones that provide a glimpse into the ongoing success we strive to achieve.
• Our Braveheart Programme is nearing completion. This 3-year business transformation has touched every area of our business and has revolutionised how we operate now – and how we support you in the future.
• We have introduced our shareholders to who we want to be through our first ever TV advertising campaign.
• Farmlands has solidified its strategy and business model with decisive action that directly benefits shareholders. An example of this is the announcement of our new partnership with Property Brokers, which you can read about on page 5.




• PigCare™ accredited ½ a leg of ham
• ¼ cup of whole cloves
• 1½ cups of water
• ½ cup of brown sugar
• ¼ cup of manuka honey (liquid honey is best)
• 1 Tbsp mustard
• ½ cup pineapple juice
Method
1. Preheat oven to 180 degrees.
2. Loosen the ham’s skin with your fingers and pull it off (warming up the ham in the oven for 5 minutes can help). Try to keep the fat on the ham.
3. Use a sharp knife to criss-cross the ham diagonally (don’t cut too far into the fat).
4. Push a clove in at each point of the diamond cuts.
5. If your ham has a hock, wrap it in tinfoil to stop it burning. Pour the water into the bottom of an oven dish for the ham to sit in. Pop into the oven for about 20 minutes.
6. After the first 20 minutes, take ham out of the oven and brush a decent amount of the glaze* over it.
7. Cook the ham for another 20 minutes.
8. Re-glaze again (if you’ve got tinfoil on the hock you can take it off now).
9. Put it back in for another 20 minutes. You might need to add a bit more water to the dish to keep the ham from drying out.
10. Re-glaze and cook for a final 20–30 minutes.
11. Once cooked, remove from oven and give the ham a final once-over with any leftover glaze. Wrap some tinfoil over it and allow to sit for about 15 minutes before serving.
* Glaze method: pop the sugar, manuka honey and mustard into a saucepan over a low heat until the sugar has dissolved. Remove from heat and stir in pineapple juice.
We are very mindful that it is about what we do, not what we say. You have heard about how Braveheart will transform our business. The challenge for each and every Farmlander is now to showcase the value of this investment through direct benefits to our shareholders. This will be apparent through a more efficient co-operative, a more effective knowledge of our business and by providing proactive support of your business, with the solutions you will need now and into the future.
Thank you for your ongoing support of our co-operative. The future is bright and we are up for the challenge. I also would like to take this opportunity to thank all of our Farmlanders around the country, who have persevered and excelled during a year of great change.
Our magazine will take a break for January, before returning in February. On behalf of everyone at your co-operative, I wish you a happy and safe holiday season. Pete.

Peter Reidie Chief Executive Officer Farmlands Co-operative Society Limited









The Property Brokers and Farmlands partnership means great things for provincial real estate*
Together our combined strengths complement each other to create a unique offering:
- over 700 staff dedicated to real estate across 64 locations nationwide
- a deep understanding of the land with market-leading expertise in property sales and marketing
- shareholders will benefit from Choices Rewards Points and exclusive discounts
Bigger networks, more buyers, better results. For more information call 0800 367 5263 or visit pb.co.nz/together
to be together
Farmlands Real Estate and Property Brokers are combining to establish a specialised, nationwide real estate and property management* service with aspirations to lead the provincial realty market.
This long-term strategic partnership will provide a broader footprint, increased scale, more resources and improved service for customers, including Farmlands’ 70,000 shareholders and Property Brokers’ provincial client base.
With settlement confirmed on 14th November, Property Brokers now owns and manages the day-to-day real estate business created from the agreement. Farmlands Co-operative will continue to support real estate through its extensive network, events, customer loyalty programme and shareholder discounts.
Via this long-term partnership, the cooperative retains its investment in real estate and will receive a contribution on future sales.
Farmlands’ farmer-grower shareholders still receive special real estate offers as part of their co-operative ownership model – including an exclusive discount on commission and Choices Rewards Points (the co-operative’s customer loyalty scheme).
A large store network has been created, with existing Property Brokers sites throughout New Zealand being supplemented by most of the cooperative’s real estate offices. The combination of breadth and depth is
something both company CEOs are excited about.
“Farmlands Co-operative has a strong network, highly regarded brand and expert knowledge of the rural sector.
Property Brokers is a business that solely focuses on real estate – we know and understand provincial property and real estate agents,” Conrad Wilkshire, Property Brokers General Manager Rural says.
“We are a growing business, and our real estate track record is backed up with strong training, systems and marketing support.”
Tim Mordaunt, Chairman of Property Brokers, says the new partnership will give the pair 20 percent share of the rural property market.
“Farmlands is one of the largest players in rural New Zealand.
Bringing Farmlands and Property Brokers together, with a network of offices, scaled-up infrastructure and a focused realty business is very exciting,” Tim says.
“Together, we aspire to grow our market share considerably.”
Farmlands Chief Executive Peter Reidie believes the partnership between the co-operative’s real estate arm and Property Brokers is a great result for shareholders.
“We are an ambitious business and to achieve the size and scale we want for our shareholders, we have partnered with a nationwide brand that has a proven track record in this highly specialised service,” Peter says.

“More customers up and down the country will now have access to specialist rural, lifestyle and residential real estate services and property management*.”
That partnership reach will take Property Brokers to over 700 staff across 64 locations, from Kaitaia to Invercargill.*
“Together, we can grow this business on a scale we could not achieve on our own,” Peter says.
Tim agrees, “We are excited to welcome the Farmlands Real Estate team into our family and are determined that this will be the beginning of a market-leading business model.”
* Farmlands will continue to administer its property management portfolio and its West Coast real estate sites, pending Commerce Commission clearance.
Farmlands Chairman Rob Hewett started in his new role at the conclusion of last month’s AGM.
You have been on the Farmlands Board of Directors for 4 years. How has that time with the Board prepared you for the Chair role?
Being a Director of Farmlands has given me a very good understanding of the business, the drivers and the people. My governance roles in other businesses have also played a part in preparing me for the challenge of the Farmlands Chair role. I’m looking forward to being able to utilise that experience and work with the skills around the Board table to help drive Farmlands forward with the management and staff.
“ Braveheart will allow the co-operative to get closer to shareholders and customers and will deliver them timely, more aligned information and services suited to their needs.
Do you feel the role of a Shareholder Director has changed as the co-operative has evolved and grown?
I think the role has changed a lot over time – and not just specific to Farmlands. New Zealand’s agri-coops have gotten bigger and therefore the fiduciary duties and bottom line consequences have gotten bigger. The increasing expectations and responsibilities of governors is not exclusive to co-operatives – you can also point to the consequences associated with fiduciary duties through companies such as Mainzeal.
What this all means for Farmlands’ Directors is that the need to undertake governance development prior to coming into the role has been amplified. That is why we promote programmes such as To the Core. It is a key activity to identify and nurture future governance talent for the business and our rural communities.
Farmlands has been on a journey of change for the past few years. How has this period prepared the co-operative for the future? The future is hugely exciting. Braveheart will be the underpinning enabler of Farmlands for the next generation. We know it is going to be very good for the business and our shareholder customers. The key will be to try to maximise its true value – we look forward to finding out how good it can be.
Braveheart will allow the co-operative to get closer to shareholders and customers and will deliver them timely, more aligned information and services
suited to their needs. I’m really looking forward to having Braveheart as the way we do business at Farmlands.
What is the Board’s vision for the next 3 years?
Our immediate focus is on getting Braveheart implemented and working solidly across the business. This is key and is the fundamental enabler for Farmlands.
Beyond this, agriculture in New Zealand is at a transition point and I think it is fair to say that the transition we are starting to go through now, as a sector, will be as wide-ranging as the changes faced by many of our shareholders (or their parents) during the 1980s. Farmlands needs to be part of the solution set for that. That will mean focusing on carbon, water, nutrient management, alternative fuels, Internet of Things, sensors, technology and continuing to deliver the products and services our shareholders require, when they require them.
To do that, we need to be even closer to our customers than we are today. Timely, relevant data is the key to unlock this opportunity – hence Braveheart and FarmIQ. This journey is going to be hugely enabling on-farm – but quite daunting. I heard a quote recently which said when it comes to farm data, it was like trying to drink from a fire hydrant. We are going to have to be very disciplined with the data that we use – we need to be measuring and using the right stuff, at the right time, working with shareholders to deliver timely and relevant information to make better informed business decisions.
“Agriculture in New Zealand is at a transition point and I think it is fair to say that the transition we are starting to go through now, as a sector, will be as wide-ranging as the changes faced by many of our shareholders (or their parents) during the 1980s.
Farmlands now has 70,000 shareholders across the primary sector spectrum. How will the co-operative continue to provide for all interests?
I think we will provide for diverse interests even better in the future because of Braveheart. We will be able to segment our customer database even more precisely. This will lead to better products and services that are relevant to you and your shareholding, from your co-operative, at the time you want them.
Our shareholder numbers have grown to 70,000, or by about 15 percent since I joined the Board. We are a preeminent New Zealand agri-products and services provider and we need to remain close to our customers to deliver value. We intend to do that.
How will the new Board structure provide improved governance for the co-operative?
The Board has reduced from 10 to nine but in that mix we now have three Independent Directors alongside the

three elected Directors from the South Island and three elected Directors from the North Island.
The Independent Director role allows the Board to appoint Directors that have a specific skill set which is complementary to our shareholderelected Directors. Given the complexity of the business in the channels that we operate, this is a good thing. The big thing about improved governance for the co-operative is our development programmes – such as To the Core. We are also helping the next generation through the Tom Cranswick Memorial Award, we have two Farmlands staff per year undertaking the Kellogg Rural Leadership Programme and have interests in a wide range of primary sector stakeholder organisations.
Talent development around our shareholder base is critical for the future of the co-operative because all existing governors are either there for a period and/or at the pleasure of the shareholders who elected them. If we want this company to continue to thrive we need sound governance, which means developing the future now.
See page 17 to read about our co-operative’s annual result.



Alpacas in Akaroa have gone viral. Atop a hill with sea views, some of the most photographed alpacas reside.
Frank and Anya Walkington are self-confessed risk-takers, but even they didn’t expect their alpaca hobby would evolve into Shamarra Alpaca Farm – an ever-growing tourism, product and genetics business.

A love of the South American camelid is the backbone of the Walkington’s success but while their story has all the ingredients of a romance novel, it has been hard work.
Their feet are now firmly on New Zealand ground but like their stock, Frank and Anya originate from afar. Frank is originally from Zimbabwe and after travelling in Europe, he and a friend recognised an opportunity and built a 65-foot schooner which they sailed to the eastern Caribbean Island of Sint Maarten. There, they began a day charter island-hopping business.
Meanwhile Anya, who was born in South Africa, was sailing in the Caribbean with her parents and when they stopped off at Sint Maarten she met Frank.
The couple geared their Caribbean businesses to meet the high-end tourism market, which the island is known for, with a construction company, restaurants and retail.
They remained on the half-French, half-Dutch 34-square mile island for 20 years before deciding to shift to New Zealand to enable more opportunities for their children’s education.
In January 2003 they moved to a 24-acre block in Wainui, north of Auckland. They started with a few cattle, but their alpaca introduction at an A&P Show was love at first sight.
A year later they had a herd of six Huacaya alpaca.
“We thought we would start small to see if we liked them and now 160 alpacas later, we think they are pretty good,” Anya says.
“We just fell in love with their personalities. They are very easy to love. The first one we bought was chosen because of its big beautiful eyes and beautiful caramel colours, it certainly was not a scientific decision.
“The first six years with alpacas was more of a hobby, although we did successfully show them at agricultural shows and had started marketing the genetics.”
The pair immersed themselves in learning as much as they could through the New Zealand Alpaca Association, conferences, other breeders, research and experts.
“We realised early on it was all about genetics and producing a high-quality alpaca that provided a high-quality fleece,” Anya says.
“So we invested in top-quality alpacas to get the good genetics we wanted and that has been our philosophy the whole way through.”
The breeding side has grown so significantly that Shamarra now sell stud stock to clients in Europe, Australia and New Zealand.
Showing alpaca at A&P Shows and the annual national Alpaca show has been a great way to market the Shamarra genetics and promote the properties of alpaca.
Last year Shamarra Diesel won the national title at the New Zealand Alpaca Show, primarily in recognition of fleece quality. When Auckland suburbia started moving too close, the couple decided they were ready for change and were keen to develop their alpaca business. They knew the drier South Island climate would be well suited to the alpaca and took the plunge, buying a 100-acre property at Akaroa – an hour from Christchurch.
The couple transported 60 alpacas to their new Banks Peninsula block, in an area known as French Farm, which overlooks the Akaroa Harbour and is a 20-minute drive from the main township.
“We were surrounded by sheep and beef farmers and I think they were wondering what this couple from Auckland was doing bringing 60 alpacas to Akaroa!” Anya recalls.
“We had three huge paddocks and no infrastructure, so the past nine years have been about building – starting with an access road and barn to provide shelter for the alpacas.
“At the beginning, we built a house which had a wing so we could provide luxury accommodation. However as the alpaca business grew, we concentrated on growing that aspect of the business.”
The move south was one month before the 2011 Christchurch earthquakes, which while devastating, was the catalyst for the alpaca farm tours. With Lyttleton Harbour out of action, cruise ships started using the Akaroa Harbour and Peninsula locals suddenly had a captive tourist market on their doorstep.
Farm tours were a natural progression for the couple who had already been involved with cruise ships and the tourism industry in Sint Maarten.

“In the beginning it was hit and miss, we were available for tours when people turned up. Since then we have fine-tuned the business and developed the market. We now run four hour-long tours daily over seven days a week, peaking in the summer season, with visitors from cruise ships, groups and independent travellers.”
The Walkington’s traditionally saw summer as their busy season but they now have a steady stream of visitors in the winter.
“We run the business as professionally as possible. We are very aware of marketing and social media and have a very complementary relationship with Tourism New Zealand and Christchurch NZ,” Anya says.
“The Chinese market has been a growth area; Chinese people love alpacas – second only to panda bears! We hire four staff over the summer, including staff who are fluent in Mandarin, although we attract an enormous international spread of tourists.
“Our visitors love it – the beautiful location, the amazing harbour setting and view along with the drawcard of the famous alpacas makes it quite unique.
“The alpacas are full of attitude, are seriously cute and very photogenic. They are happy to be hugged, everyone wants a selfie with an alpaca. Their fleece feels amazing.
“Our alpacas are very comfortable with tourists. It is a handson interactive experience. The tours are in large paddocks, supervised by us or staff. Animal welfare is our priority, the alpacas all have different personalities, some are forward, some are aloof, and we respect that.”
Anya says they have a personalised approach which the visitors like. With alpacas being “very gentle animals”, the family has named all of them and know each of them individually.
“Visitors turn up asking to see an alpaca by name!”





Anya says ‘Rising Sun’ is her favourite.
“He is our game-changer, a breeding male we imported from Australia.”
The couple say the health of the herd is paramount.
“Animal husbandry is very involved and our breeding is selective. Our focus is about a quality product across everything we do,” she says.
The birthing season is from December to March and the baby alpacas, cria, are exposed to tourists from just a few days old.
“We have scope to grow our herd size to 200, but we don’t want to compromise quality with quantity or lose our personal touch.
“Keeping it intimate is important for the alpacas too, they need their rest as well.”
The Walkington’s high-end, New Zealand-made alpaca products use natural undyed fleece and are manufactured sustainably. The luxurious Shamarra alpaca knitwear is now a significant part of the business and an area they are growing from a digital platform.
Anya learned to knit as a young girl so had always had an attraction to fleece and fibre. She could see a future in the fleece and started developing a market.
“We now process four tonnes of alpaca fleece a year with the knitwear products designed and manufactured in New Zealand.”
Yarn is produced from fleeces that have been individually micron tested with the high-quality Sovereign range featuring 16-18 micron and 24-26 micron for blankets and throws, all in the alpaca-rich natural colours.
“It is fraught with risk at every step and is an intricate supply chain process as we breed the animals, source the fleece and produce the products. Quality is the baseline in everything we do.”
The product range includes blankets, jerseys, beanies, scarves, ponchos and wraps sold from the farm shop and online.
The couple say there are moments when they sit back and pinch themselves and wonder how it has all happened.
They are pleased to have set up a succession plan with their daughter Alex keen to take on the operation while sons Eric, who is in the hospitality business and Ben, a pilot, will continue with their careers.
“We are passionate about alpacas, it’s not like we are going to work every day. In the Caribbean we tried to expand our businesses as much as we could but now we focus on quality and enjoying what we do,” Anya says.
Gain nutritional advice for alpacas on page 33.

Found high in the Andes Mountains of Peru the alpaca is a gentle, mystical creature with strong bonds to their human keepers.
Alpacas have provided fleece for thousands of years. The ancestors of the ancient Incan people wove fabric from the fleece of the alpaca that was so soft and so luxurious it was prized above all else and considered more valuable than gold. Alpaca fleece was known as ‘The fibre of the Gods’ and was reserved only for royalty.
The invasion of Peru by the Spanish Conquistadors in the mid-1500s led to the wholesale slaughter of the alpaca herds and their Incan keepers and to the destruction of the Incan empire.
The few ravaged alpaca herds that survived the slaughter were secretly moved to the barren and remote mountains of Peru.
It was not until the mid-1800s that alpaca was rediscovered. Since then they have slowly gained prominence and today are once again appreciated for their qualities and the natural beauty of their fleece.

For centuries it is the alpaca’s fleece that allowed the animals to defeat the chilling wind and freezing cold.
The natural fleece does not have to be dyed and grows in more than twenty rich, natural colours – from shades of dark charcoal to warm fawns and creamy whites.
Alpaca is the only animal in the world that produces such a large variety of natural colours. The fleece is sustainable, renewable and ecologically friendly. Alpacas can easily grow enough fibre to produce two or three jerseys in a year with an annual fleece growth of around 100mm.
Anya says all their Shamarra knitwear products are exclusive to them and celebrate the virtues of the fleece.
Alpacas have a minimal effect on the eco-system with their soft, padded feet gentle on the terrain.

There are a total population of four million alpaca worldwide with the alpaca female only producing one offspring each year. Twins are very rare.
The Walkington’s have based their knitwear business on the fact that today’s consumer demands high-quality, environmentally friendly and sustainable products made from naturally renewable resources.


Whether you’re headed to the beach, the bach or having some well-earned R&R this Christmas, make sure you take advantage of your All Together Better Choices Rewards programme. With gift vouchers, market-leading merchandise and eVouchers sent directly to your phone now available, head online to start redeeming.














Spend at Farmlands stores during December and receive DOUBLE POINTS on your purchases.
Make sure you’re rewarded for more of what we do together, head into your local Farmlands store today!


6,400

















11,200


43,000



5,000































On Thursday 31st October, Farmlands Co-operative announced its annual result for the year ended 30 th June 2019 to shareholders.
Outgoing Farmlands Chairman Lachie Johnstone says the rural supplies and services co-operative achieved another positive result for its shareholders against the backdrop of a subdued marketplace and challenging on-farm conditions, particularly in spring 2018.
“Farming uncertainty has dominated short-term decision-making on farms across the country,” Lachie says.
“This has inevitably had an influence on our performance. However, our 2019 result represents a further step along the path of building resilience in our business.”
Farmlands’ net profit before tax and rebates for the latest year is $8.4 million on revenue of $1.1 billion. Total revenue has increased by 3.2 percent on the previous year.
While expressing satisfaction at Farmlands’ continuing profitability, Lachie says that the Board of Directors has decided not to distribute an additional Bonus Rebate to shareholders in 2019.
“We came to this decision extremely reluctantly. However, Farmlands is navigating its way through a big and very demanding change programme, Braveheart. This programme is designed to future-proof Farmlands for the next generation and beyond.
“The Board believes the decision not to pay a Bonus Rebate this year is prudent in light of the significant cash commitment to the Braveheart project and its ongoing impact on the business balance sheet and cash flow, compounded by sector uncertainty. Retaining cash at this time
supports managing the co-operative’s seasonal liquidity requirements as well as funding the completion of the Braveheart Programme.”
Farmlands Chief Executive Peter Reidie says the co-operative is pleased to post another year of growth and profitability for Farmlands shareholders.
“We’ve succeeded in delivering $86.1 million in rebates to shareholders on their Farmlands Card activity and at point of sale and have delivered $6.7 million worth of Choices Rewards Points.”
Peter says that Farmlands is also positioning itself as the sector leader in the area of health and safety, training and environmental stewardship — a function of the co-operative’s commitment “to put our people first”.
“Last year, with our FarmIQ partners, we launched SafeFarm. Earlier this year we launched our second safety app, SafeVisit, which is free to all New Zealanders. SafeVisit provides visitors with a way of scheduling visits and completing a full site induction in advance using the app,” Peter says.
“Our development of training programmes and our focus on environmental stewardship have been recognised across the Asia-Pacific, notably with our Farmlands Darfield store being lauded at the Environmental Respect Awards earlier this year.”
At the conclusion of last month’s Annual General Meeting, Lachie Johnstone stepped down as Chairman, after serving nearly 19 years on the Board. Rob Hewett has replaced Lachie as the new Chair.
“It has been my privilege to have watched Farmlands grow its footprint nationally. It’s now a nationwide cooperative, providing all the products
Farmlands Net Profit Before Tax and Rebates ($m) Farmlands Revenue ($b) $1.1b Farmlands Gross Turnover ($b) $2.7b
$8.4m
and services our 70,000 shareholders need to succeed in business. We’ve created a business that has an entire value structure built on giving back to those that trust us to help them with their livelihoods,” Lachie says.
“I’m handing over to Rob Hewett confident that Farmlands is in good heart. Through our ‘To the Core’ programme, in conjunction with Silver Fern Farms, we’ve made a major effort to foster the next generation of rural governance. This initiative, in tandem with our Braveheart business-wide transformation programme, means our co-operative is positioning dynamically for the future –a future that we see is full of promise.”
Farmlands also farewelled Director Murray Donald following the AGM.
To download the 2019 Farmlands Annual Report visit farmlands.co.nz/annualreport




The winners of this year’s Tom Cranswick Memorial Award were announced at the Farmlands Annual General Meeting in November and once again, the calibre of entrants was exceptionally high. Each recipient is currently taking part in a course of study directly related to the primary sector and has been awarded a grant of $2,000 to help them through study, to see them contribute further to primary industries in the future. Each recipient was asked: What is the biggest challenge facing the primary sector in New Zealand today? What would they do to overcome or meet that challenge?

With a desire to pursue a career in Farm Management Consultancy, Rachael is currently studying for a Bachelor in Agricultural Science at Lincoln University. Rachael has recently spent time at Colorado State University in the United States, studying large-scale agricultural systems, gaining valuable insight as to how New Zealand agriculture is perceived by the rest of the world. Hailing from Motueka, Rachael is a keen rugby player and was elected for the Tasman Mako Women’s Sevens team which successfully competed at last year’s national tournament in Tauranga, winning the bowl final.


The greatest challenge facing the primary sector is the communication breakdown between rural and urban New Zealand regarding environmental impact. An industry that is constantly being talked about in a negative way does little to encourage young people to enter the industry. Creating an atmosphere that people respect and understand will go a long way to reducing the divide between New Zealand’s primary industries and the urban population. The agricultural industry is known for holding advisory days that showcase how innovation is helping to overcome the adversity faced by their industry. These events should be seen as opportunities to educate different demographics on how primary industries are responding to issues such as environmental impact.


Living on a Northland farm for most of her life has given Hannah a tremendous introduction to her Diploma in Agriculture at Lincoln University. Not stopping there, Hannah hopes to move on to Farm Management and then a Bachelor in Commerce; all underpinned by her ethos of working hard, being patient, developing resilience and learning by doing. Hannah’s achievements are not all on the farm either. She has been a student councillor, president of the Dargaville High School Teen Agricultural Club and captain of the Collegiate Hockey team. Once her studies are finished, Hannah has her mind set on becoming a Farmlands Technical Field Officer.

Sustainability and climate change are the major challenges we are facing today. With the rapid rate of change within the sector in terms of technology, farming practices, laws and regulations it is important that we are informed, educated and able to embrace those changes. After completing my studies at Lincoln University, I would like to become a Technical Field Officer. The position would enable me to source the latest products and services and up-todate information for farmers to integrate into their farming practices. We must still aim to improve productivity while we continue to evolve as the climate changes around us.






Growing up on a North Waikato sheep and beef farm, there is very little Jacob has not done on the land in his 20-odd years. Cropping, pasture conservation, water system installation, fencing – It has all stood him in good stead for his Bachelor of Agricultural Science with Honours at Lincoln University. When Jacob is not studying you will find him getting more practical experience to guide him into a role with Farmlands. One day soon it might be Jacob providing you with advice on forage cropping, regrassing and pasture management, or maybe sharing his love of mountain-biking with you and the routes he discovered on his travels.


The society we live in today has an ever-growing rural-urban divide. The only knowledge that the urban community has about farming is what is received through social media, the news and print media. This potentially opens the possibility of anyone being able to publish anything they see fit, regardless of accuracy. The issue is that if one “bad” photo gets out or a negative opinion is shared, then this could be seen as fact with assumptions made about farming as a whole based on this. To protect the future of the primary sector in New Zealand, the urban community needs to be properly educated by the farming community. This will allow farmers to show them the passion they have for their chosen way of life. The ‘urbanites’ will then be able to understand that farmers respect their livestock, as healthy animals drive production. Farmers will also be able to explain and show the efforts they are making to reduce the impact on the environment.

New Zealand agriculture is facing some mighty challenges and these are likely to seem even bigger in the future. Lab-grown meat is reality, soy and almond ‘milks’ are taking shelf space from traditional cows’ milk and environmental and animal welfare concerns are shaping consumer demand. These challenges have real potential to disrupt, challenging the way we farm. I want to be part of the solution and I’m looking forward to educating our domestic and offshore customers about the benefits of consuming ethically-raised, free-range, grass-fed red meat. The numbers do not lie – we have got a great story to tell and it is going to require a mix of facts and emotion to make sure we can continue selling our premium food and fibre at the best possible prices.


Majoring in International Agribusiness at Massey University, William is furthering his academic and agricultural ambitions by taking part in a 5-month exchange programme with Shanghai University in China. From his chosen course of study and indeed this exchange, William hopes to pursue a career integrating both business and the dairy industry. Diving head first into a new culture is not the only area where William has excelled. He has completed the bronze and silver sections of the Duke of Edinburgh Award, with the gold on its way; taken on the role of the Massey Young Farmers’ Publicity Officer and was the youngest winner in 60 years at the Young Farmers Stock Judging Competition.

Pushing herself to be the best she can be is a way of life for this Agribusiness and Food Marketing student from Lincoln University. Harriet has been a lover of the great outdoors from an early age, riding horses, taking part in multi-sport events and now competing nationally as a sprint kayaker. Her achievements are not limited to the outdoors either as Harriet consistently earns high grades in her degree course and through her part-time work with ANZCO Foods. She helped put together Being Bold For Change, a conference aimed at empowering and supporting women in agriculture.

Environmental sustainability is a discussion not unique to New Zealand nor the primary sector. However, changing the negative perception of the industry by the general public is especially important. Though arguably un-restorative, much of New Zealand’s primary industries are world leaders in environmental measures such as CO2 produced-peroutput and water use-per-output. However, this is seldom presented through general and social media. I believe that this misinterpretation of New Zealand as an agricultural producer is holding the industry back. It is disheartening to those involved in the industry and often disincentivises further environmental action. It also underutilises, what I believe to be, New Zealand’s strongest selling point in international markets: the sustainability of NZ production. If we can shift New Zealand’s perspective towards its primary systems as something to be proud of, I believe it will further incentivise sustainability while driving the profitability of the industry.









We know farming never stops. But taking some time out to spend with loved ones and look back on all you’ve achieved in the past year is the first step to a happy and prosperous 2020.
This means your local Farmlands store will be closed on:
Wednesday 25th December
Thursday 26th December
Wednesday 1st January
Thursday 2nd January
To make sure you’ve got access to all the products and expertise you need over the festive season, Farmlands will be trading as normal every other day.
Opening hours for your local store can be found by visiting www.farmlands.co.nz/StoreLocator
Farmlands wishes you a safe, happy Christmas and a cracking New Year.
While New Zealand is still working to eradicate Mycoplasma bovis most Kiwi farmers have escaped the dreaded positive test. This can be credited in part to the processes put in place by Livestock Improvement Corporation (LIC).
LIC’s protection of dairy herds throughout the country was recognised by Biosecurity New Zealand at their annual awards dinner on 4th November, with the agri-tech co-operative taking home the New Zealand Biosecurity GIA Industry Award.
The Biosecurity Awards celebrate individuals and groups across New Zealand who have rolled up their sleeves to strengthen the biosecurity system. The judging panel was impressed with the commitment made by LIC.
“This win reflected the incredible effort undertaken, which was fundamental to protecting LIC’s core business. Mycoplasma bovis could have been an ‘existential’ risk for LIC and they really lifted their game,” the judges reported.
A finalist for both the GIA Industry Award and Mondiale Innovation Award, LIC’s work has been a critical piece of the Mycoplasma bovis prevention puzzle. As the largest supplier of artificial breeding services to New Zealand’s dairy farms, over the past 18 months LIC has developed and implemented comprehensive, MPI-approved, biosecurity protocols that have helped to prevent the disease from spreading between customers and across the country. LIC have gone above and beyond, overturning their business-as-usual processes to instigate stringent testing
regimes across all of their business operations. Protocols include:
• bull semen tested daily with results confirmed before any samples are dispatched
• routine tonsil swabbing of live animals
• blood testing
• additional antibiotic added to the semen diluent
Mycoplasma bovis has not been detected in any sample, however the robust regime has not faltered and will continue during this year’s peak mating season.
Upon receiving the Industry Award, LIC Chief Executive Wayne McNee stressed the importance of vigilance when working towards eradicating the disease.
“It’s critical to LIC and the dairy industry that we continue to take all possible measures to protect our bulls and effectively manage any risk of transmission by our staff or equipment,” Wayne says.
LIC’s additional biosecurity measures ensure every point of contact with farms is addressed. All herd testing

equipment that comes into contact with milk is disinfected between farms while LIC staff disinfect themselves when arriving and leaving farms.
“Our industry has been dealing with this significant challenge since July 2017 and we can’t afford to become complacent. It’s critical we don’t give up on the eradication effort,” he says.
Biosecurity NZ Awards recipients included:
• Supreme Award and the Community Pihinga Award (for new initiatives): Te Arawa Lakes Trust: Te Arawa Catfish Killas.
• Minister’s Biosecurity Award: David “Didymo Dave” Cade.
• Emerging Leader Award: Kane McElrea of Northland Regional Council.
• Mondiale Innovation Award: Automotive Technologies Limited.
• Bio-Protection Research Centre Science Award: Myrtle Rust Research Consortium.

Read about the other Awards recipients at biosecurity.govt.nz/new-zealand-biosecurity-awards





A new initiative to better support small businesses has been launched in Hawke’s Bay by the Minister for Small Business, Stuart Nash.
Combining face-to-face coaching events with the latest online support tools, the Kiwi Business Boost is a pan-sector initiative backed by more than 60 partners, including Farmlands Co-operative.
The first event in the Kiwi Business Boost series of regional coaching workshops was held on 8th November in Wairoa. As part of the pilot launch, 50 free events ran over two weeks, giving hundreds of small business owners and their staff access to hands-on mentoring and advice in Wairoa, Napier, Hastings and Waipawa.
“These events will offer help with some of the biggest challenges businesses face: cash flow, staff, sustainability, legal obligations, and health and wellbeing,” Stuart says.
The Kiwi Business Boost initiative has been researched, tested and delivered with input from its partners from across the public sector, business, not-for-profits and industry groups.
The concepts were also tested with more than 200 small businesses from around New Zealand.
“Despite the growth in online technology over the past 20 years, some of the fundamentals of running a small business have not changed. We know it can be really tough. Business owners need to manage customers, staff, sales and legal obligations – usually on top of family commitments,” says the Minister.
“Business owners often say they don’t know who to turn to for advice or just to talk through their day-to-day issues,” he says.
“We are encouraging businesses to build their support network and seek out business mentors. Small business in the regions can be hard to reach, and often say they feel isolated. The Boost initiative is a pilot scheme to see if we can break through that barrier.”
The workshops covered topics such as:
• Getting started with a business
• Managing growth via technology and finance tips
• Keeping on top of risk and operations
• Best practice for tax and accounting
• Staff management, including leadership skills
• Sustainability and wellbeing
Stuart says the lessons learned from the Hawke’s Bay events will be rolled out to other parts of the country.
As part of the regional support offered, Farmlands Co-operative ran workshops on Digital Readiness and Farmlands Hastings promoted Boost events.
Farmlands Director of External Relations, Mark McHardy says that support for small businesses does not end when the event does.
“Using a cutting-edge customer interface, the Boost website enables small businesses to identify their particular issue/s. The scenario-based technology prompts owners and their staff to drill down into the most relevant and specialist resources to address their business ‘pain points’. The beauty with this approach is that people don’t get bogged down in information that isn’t relevant to them,” Mark says.
“Whether it is staff pay, retention or leadership you need help with – or


identifying how to access finance and deal with environmental issues – you can customise what you see by clicking on which situation applies to you.
“This specialist small business resource is a total game changer and you don’t even need to leave home to benefit,” he says.
Other partners include New Zealand Trade and Enterprise, Hawke’s Bay Business Hub, Inland Revenue, PopUp Business School and more.
Get started today at www.tools.business.govt.nz/boost





































It p out for a while neworflexyourfishinng rod canimpro





It can be a tough gig working out on the farm in the summer. We know you love it but it’s always nice to skip out for a while. Taking time to practise a hobby, go somewhere new or flex your fishing rod can improve general wellbeing and helps reset your engine for the year ahead!

We caught up with a few of our shareholders and staff members who are taking a breather this summer, heading off-farm to explore something new, both here and abroad!






ALEXANDRA to EUROPE







CHRISTCHURCH to WEST COAST
Rapid chasing
Glad Narayan, Farmlands Senior Payroll Advisor
Unlike most who chase the sun, Glad chases the rain. A beginner paddler, Glad travels to the West Coast most weekends during the summer to paddle down the whitewater of alpine valleys. Accompanied by a group of experienced paddle-keen mates, they pick and choose their rivers based purely on what the weather has been doing during the week. A low river makes for tough paddling, but the deeper the water, the greater the risk.



Cruising through the Christmas Markets
Sylvia Winsloe, Shareholder – Caregiver
Tired of the dreary Central Otago winter, Sylvia Winsloe decided a different type of cold was on the cards and is off on a “Ladies only” river cruise through Europe!
Organised through Tony and Tracey Laker at House of Travel, Sylvia will leave her peony roses behind to tick another trip off her bucket list. The tour’s first stop will be in Dubai before starting the cruise in Prague. The ladies will float through to Nuremburg, Regensburg, Passau, Vienna and Budapest, taking in the magnificent Christmas markets filled with the smell of gingerbread and dazzling light displays. “It’s nice to do something different for summer, we might even get snow on the river!” says Sylvia.

















Brooke Stewart, Farmlands Salesperson
Not being able to use her phone for 21 days will be Brooke’s biggest challenge when taking on Outward Bound this summer. Brooke grew up in the hill country of Taranaki and loves getting outdoors. Set in Anakiwa, just out of Nelson, Outward Bound is known for its toughness, with participants getting involved in activities such as rafting, camping, sailing and a half-marathon. Brooke isn’t worried about the physical side of things though as she’s been training at a Crossfit gym, she’s more excited to expand her connections. “I don’t know anyone else going so I’m really keen to meet new people!” says Brooke.








Michael and Solveig Northcote, Shareholders – Highfield Station
It’s a trip down the Forgotten World Highway for Michael and Solveig Northcote this summer. After flying into New Plymouth, Michael and Solveig will follow the winding road south around Mt Taranaki before heading 45 minutes inland from Stratford to a little community called Makahu. Named after the mythical “white hawk”, Makahu is the home of lush native bush, fresh-water springs and pioneer living. Exploring the bush, diving off floating jetties into farm lakes and finishing the trip with a classic community hall party, Michael and Solveig will experience WIFI-free living at its best.











Fishing the dream

PATOKA to TAUPO Pedal power
Greg Thomson and Emma Booth Shareholders – Lindholm Limited
A couple of hours drive from Hawke’s Bay sets Greg Thomson and Emma Booth right at the shore of the beautiful Lake Taupo. Accompanied by their little dog Ollie, Greg and Emma take a few days off the farm to relax with their family and friends. Starting most days with a bike or wander around the lake, Greg and Emma take advantage of the cool mornings to get their exercise out of the way before the sun heats up. The afternoon is for swimming and socialising with plenty of places to eat along the lakeside. “It’s a chance to reset and relax for the next year,” says Emma. “Plus, we get in some quality family time.”

Richard Hill, Shareholder – Flock Hill Station
A full weekend out in the Akaroa harbour is on the calendar for high-country farmer Richard Hill. Although he doesn’t get out as much as he’d like, the lure of a big catch will tempt Richard out to the little French-infused town more than once this summer.


Starting the morning beyond the harbour, Richard, accompanied by his family and friends, fish for blue cod and grouper while the sun comes up. Once the catch has filled a chilly bin, the crew will pop on their diving gear and jump off the boat to dive for crayfish.

A quick jaunt back to the pier for a cuppa and to drop off the diving tanks resets the energy levels before getting back into the water to free-dive for paua. “It’s a completely different environment from the farm,” says Richard, “we love it.”






If you’re heading out and about this summer, stay safe on the roads, pop on a hat and slap on the sunscreen.
Farmlands wishes you a happy and healthy festive season!




Good irrigation means greener pastures and higher yielding crops in the drier months. Great irrigation achieves that using the least amount of water and power as possible.
The best irrigation is supported by a power company that knows your system, farm and electricity usage inside and out.
That is the message from South Canterbury farmers and Meridian Energy customers, Michelle and Leighton Pye. The couple own and operate Pye Group – a family business spanning dairying, vegetables, cropping, grazing, contracting and transport.
For Leighton and Michelle, the relationship with their Meridian Agribusiness Territory Manager, Jamie Robinson, has helped them get the best out of their power. Having direct access to a dedicated manager is one of the main reasons they chose Meridian –and continue to, 15 years on.
“That is so important for us. With Meridian you have someone who knows who you are, knows your business, knows your account, knows what you’re talking about… you don’t have to re-tell your story. It makes life simple,” Michelle says.
The Pyes also value being able to pay their entire group’s Meridian bills through Farmlands. This includes power accounts for dairy, grazing and cropping farms.
“We’ve found that is hard to replicate elsewhere with other suppliers,” Michelle says.
“Farmlands aren’t there to make money, they’re there to help and benefit their members. We find that Meridian have the same philosophy – they’re there to help us. That’s the reason we’ve had such a longstanding relationship.
“Our relationship with Jamie is great. He’s approachable, has great industry knowledge, and wants what’s best for us.”
For an operation of such scale, you can imagine the effect irrigation has on the power bills.
“Most of our sites are irrigated, so it’s our biggest user of energy by far, up around 90 percent,” Michelle says.
The Pyes have found that sustainability initiatives help them be smarter with irrigation. The Group is constantly learning and improving their practices and has recently employed an environmental manager.
“Until lately we’ve been about compliance, and we want to move more towards enhancement – we’re getting more deliberate about it,” she says.
“Being more sustainable benefits the environment, which we think is really important. Anything we can do to save on water and irrigation for example, helps us save power, which benefits the bottom line too.”
As water is Pye Group’s biggest use of power, moisture probes, bucket tests
and telemetry have all helped improve water and power efficiency.
“We’re constantly monitoring it so we’re only irrigating when we need to – and we can actually get more growth that way,” Leighton says.
Jamie commends the couple for keeping a close eye on their on-farm power use.
“These guys have an in-depth knowledge of how much power everything uses, and the capacity of each of their sites… they’re really switched on,” Jamie says.
“Irrigating wisely makes a massive difference to farmers’ power consumption. We can help streamline that even further by making sure our customers are on a fit-for-purpose power plan that suits their irrigation volume and regularity.”
Jamie’s regular account audits also ensure the Pyes’ electricity plans work for their farms’ specific needs.
“It’s horses for courses. I look at which sites should be on seasonal or year-round rates, and consider meter configurations too, ensuring they’re on the money and Pye Group is only paying what they need to,” Jamie says.
“Lots of farmers have no idea what they’re looking at when they get the power bill, but we can help sit down with them so they’re aware of what they’re paying for.”
And it goes further than that, Jamie says. Paying a farm visit is so much more effective than a phone call or email, and it means Meridian and the customer has a better lay of the land.
“For example, Leighton and I spent a day in the car going around all the sites coding and labelling each meter – so we’re exactly sure which pump is which and how much it’s using.”
Dairy sheds are also prime candidates for energy-saving initiatives, he says.

“There’s heaps we can help with. We’ll benchmark sheds against national averages and trends, identify why some sites might be using more than others and work out how to bring that down. Our dairy-specific plans have fixed-rate options that can be tailored to each farm’s needs – so we can make it work for each farmer.”
The door is always open
For farmers who are keen to learn more about what Meridian can offer, Jamie says the door is always open for a cuppa and a chat.
“Give us a call – we’ll sit down with you at the kitchen table or office, go through your power account and give you a noobligation comparison to see how we stack up against your current provider,” says Jamie.
“We’ll also let you know how we think you can reduce your power use and costs and how we can help with that.”
Michelle and Leighton encourage farmers to take a serious look at switching to Meridian for dedicated service, competitive prices and the convenience and benefits of paying the bill through their Farmlands Account.
“We couldn’t recommend Meridian highly enough,” Michelle says.
“We’re yet to come across another power company with dedicated agri managers that will understand your business as well as Meridian does. It’s not all about price, it’s about relationships too. And Meridian is a hands-down winner on both.”
For a free, no-obligation plan comparison, give the Meridian Agribusiness team a call on 03 363 5104 or to find out more about the Farmlands and Meridian relationship visit farmlands.co.nz/MeridianEnergy
Article supplied by Meridian Energy.











New Zealand has a rich history of farms being passed down through generations says Al McCone, Agricultural Lead for WorkSafe New Zealand.
“Some families have a history stretching back as far as 170 years or more on their farms. You don’t achieve that kind of legacy without instilling a passion for farming in the younger generation,” he says.
This summer, children will be out on farms across the country – playing, doing chores or, even the very young ones, ‘helping’ mum and dad.
“Summer offers an opportunity to create safety champions of the future,” says Al.
“When you make safety decisions for children, such as areas they can’t go, high-vis clothing or washing hands after touching animals, explain why.
“Walk around the farm and identify hazards together. When they’re going to help with a job, talk through the risks and how you’ll manage those safely.
Lead by example – like always wearing an approved helmet on a farm bike or quad, and wearing a seat belt in all vehicles. Children will grow up seeing that as simply the way things are done.
“Young brains soak up information. They can forget it fast too, which is why it’s also essential to be constantly vigilant and the younger the child, the more closely they need to be supervised.
“By continuing to share those safety messages and demonstrating safe practices in action, you will be helping safeguard their future and the future of your farm business – because a safer business is a stronger business.”

Other key points to note are:
• Consider having safety fences around play areas, animal pens, work areas and water spots.
• Lock doors in areas where children should not go.
• Use safety guards on all machinery.
• Store agri-chemicals out of children’s reach.
• Remove keys from doors and vehicles. Never leave vehicles unattended with the motor running.
• Walk around farm vehicles and check children are a safe distance away before starting the engine.
• Children should not ride on tractors, quad bikes or on the back of utes.
• Children should be in car seats and seat belts when in cars, utes and trucks on public and private roads.
Every year many children are injured on New Zealand farms. ACC figures show that more than 100 children hurt themselves on quad and farm bikes annually. About 28 are hospitalised and
• Cover tanks and wells with child restraint covers or fill in disused ones.
• Tie spare tractor wheels to walls or lie them flat.
• Make sure children ride bikes appropriate for their age and height and which are in line with manufacturers’ specifications.
• If children are riding a smaller model farm bike, they need to wear an approved helmet and closed-in shoes and be under constant adult supervision.
• Make sure effluent ponds are fenced with waterproof fencing and children are supervised near water – such as easily accessible drains or races and ponds.
between three and six die. Other main accident causes are animals, accidents suffered on or near tractors, water hazards and farm machinery.
Article supplied by WorkSafe.


















Articles in the Plan365 section allow Farmlands suppliers to share best practice and the latest advances in rural technology, to help shareholders with their farming needs all year round.
It is that time of the year when we like to treat our loved ones but what about your chooks, surely they deserve a Christmas treat too? Products available can stimulate chickens to exhibit more of their natural behaviours, increase their enjoyment of life and improve their health and wellbeing.
Chickens can get bored, especially if they are not getting positive reinforcement from foraging in their environment. This can lead to birds pecking each other, as they still want to exhibit their natural pecking behaviour, leading to some chooks being bullied and losing feathers. A great way to curb this behaviour is to give them something else to peck at, such as Topflite’s Poultry Pecker which is full of goodies such as grains, sunflower seeds, peas, garlic, mealworms and herbs. You can even try some homemade options to keep them occupied, such as a pumpkin with holes drilled in it.
The early bird gets the worm but with your help, the latecomers will get their chance too! Topflite Dried Mealworms are a healthy, nutritious snack filled with protein and for a summertime treat, why not make some mealworm ice cubes? Put a few in the cube tray, sprinkle in some herbs or grains and freeze. Set them out in a pan in the shade and your chooks will be kept busy for a while.
An automatic feeder
An automatic feeder, such as a

| Chickens pecking at a Topflite Poultry Pecker.
Feed-o-Matic, is a great Christmas pressie for your chooks, especially if you are heading away over Christmas and the neighbours are keeping an eye on them. The great thing about using an automatic feeder is that the chicken steps on a lever to open the lid (which they learn very quickly) thus keeping the food fresher for longer and away from vermin and wild birds. It also ensures that your chickens have access to a buffet of layer feed, which helps to support egg production. Remember to keep your chooks topped up with fresh water this summer – water bowls connected to a reticulated water system are a great way to ensure birds have as much clean water as they want.
NRM Peck’n’Lay
Now you have got the automatic feed sussed, why not fill it with a high-quality chicken feed? NRM Peck’n’Lay is a premium layer feed designed to provide essential nutrients for egg production.
With balanced energy and protein, vitamins and minerals, a natural yolk colourant extracted from marigold and paprika and essential oils to support optimum gut health – it will keep your chooks in optimum condition. Make sure feeders are always topped up with layer feed as this should be the main part of their diet.
Why not take advantage of the time off, buy some deer posts, a deer gate and fencing from Farmlands and super-size your chook’s foraging area? Space gives more chance for plants to survive and gives birds more space and freedom. Fruit trees can increase the production from the land, shelter birds from the sun and help them to feel safer.
For further information, contact your Nutrition Specialist or the friendly team at your local Farmlands store. Article supplied by Stacey Cosnett, NRM Nutritionist.







































Alpacas and llamas have endearing personalities and are great companion animals for people with land. They are generally long living, hardy and “good doers” — naturally selected over millennia to survive in the dry, barren regions of South America.
They do not typically require a high level of supplementary feeding. For non-breeding stock obesity may be more of an issue than trying to keep weight on but they have some unique challenges when living so far from the equator and may benefit from a little supplementation daily.
Vitamin D deficiency
Vitamin D (the ‘sunshine vitamin’) deficiency is common in alpacas and llamas and is exacerbated in the winter months due to decreased sunshine hours. Vitamin D plays an important role in bone development and deficiency during pregnancy and lactation can cause rickets in young cria, due to low vitamin D in the colostrum and milk. Supplementing pregnant and lactating alpaca with vitamin D is a necessity however non-pregnant and male alpaca will also benefit from vitamin D supplementation year-round too.
Thiamine deficiency
Polioencephalomalacia (PEM), inflammation of the brain due to a thiamine (vitamin B1) deficiency, is a condition more commonly seen in alpaca and llama compared to other animals. The gut flora of pseudoruminants like alpacas and llamas usually produce enough thiamine to
satisfy animal requirements however thiamine production can be reduced in certain circumstances. Regular supplementation of thiamine helps prevent PEM arising. Once an animal is showing signs of neurological impairment, injected thiamine is required quickly to avoid death. During the year, additional vitamin D and thiamine may need to be administered to alpaca as per vet recommendations particularly for pregnant alpaca and young cria.
Coccidiostats
Oddly, these animals are very sensitive to the ionophore lasalocid (Bovatec®) which is used to control coccidia to which camelids are also prone. Extra care should be taken to ensure they are not given access to medicated calf or dairy feeds.
Facial eczema
Alpacas and llamas seem especially sensitive to facial eczema. Fungicides can be used to reduce the spore challenge or pasture can be excluded from the diet. High levels of zinc supplementation aids in the prevention of facial eczema. There are zinc products intended for cattle and sheep that people can buy including: bullets, zinc oxide for dusting or mixing into feed, and zinc sulphate for water treatment. Commercially, NRM can only add and promote a product with high levels of zinc that is registered for the class of animal being fed. Because of the small size of the market, zinc importers are reluctant to go through the registration process for alpacas and

llamas so at the time of writing I cannot formulate an alpaca product with zinc above normal nutritional levels.
Take-home message
Opting for a specialist feed ensures the particular needs of these unique animals have been taken into account. Feedback on the new NRM Alpaca Pellets, which are formulated from nonGMO ingredients, has been fantastic. For those owners that prefer to feed a textured feed when trying to mask medication, the Alpaca Pellets can be mixed with chaff and a little molasses. For more information contact your NRM Nutrition Specialist or the friendly team at your local Farmlands store.























MIDEA 3.5KW HEAT/2.9KW COOL PORTABLE AIR CONDITIONER WHITE
• 3.5kw cooling, 2.9kw heating capacity • White finish
• 0-24 hour timer setting with sleep mode • Dehumidifying function
• Self-evaporative system, no draining required under cooling mode
• LCD remote control • Warranty: 24 months • Window kit included for only sash and sliding windows

MIDEA 26 SPEED REMOTE CONTROL PEDESTAL FAN WHITE
•
• Five Modes: Comfort, Mute, Nature, Sleep, Normal 3801972

MIDEA 3 SPEED REMOTE CONTROL TOWER FAN BLACK
• 3 energy-efficient speeds • Simulating natural, slumberous & normal wind • 7 hours timer • Oscillation for broad room coverage • Remote control • Elegant home furnishing fashion, stylish design 3801973


3800375 CAMPING CHAIR





• Black & grey with blue trim
• 112kg load rating
7721543




• Cushioned back & seat for ultimate comfort












• Features various compartments for storing drinks & food



























The Wilson family and McMillan Equine Feeds have enjoyed an exciting journey over the last 10 years and in partnership they have grown into a force to be reckoned with in the equestrian world. As sponsors, the team at McMillan provide support and guidance on feeding to the horse-loving family.
Simon, Claire, Tim and Anna Wilson are a farming family from Central Hawke’s Bay. Based on Mount Herbert Farm, near Waipukurau, the whole family are heavily involved with various equestrian disciplines.
They spend the summer months touring the countryside with a team of nine showjumpers on the truck. This includes homebred youngsters, some ponies and a couple jumping at the higher levels. Both Simon and Claire have been past Olympic Cup winners and New Zealand team representatives, so they understand exactly what it takes to produce horses performing at the best of their ability. McMillan has a wide range of feed available for competition horses, who each have different requirements. Given the large number of horses the family competes regularly, there is a wide range of different types with different nutritional needs. The majority of the Wilson’s showjumpers receive Sport Horse, a high-quality, steam-flaked grain mix that is ideal for providing a balanced level of required nutrients as well as an optimum blend of energy sources to support both fast and slow-release energy requirements. Any horse requiring additional calories and protein for weight gain and maintenance while competing receives Rapid Gain, a highly versatile

steam-flaked grain blend that is ideal for providing additional digestible protein and fat for conditioning.
Simon also trains a few racehorses, with the 2019 Winter Cup winner Dez, being his most successful.
Dez’s achievements were even more rewarding considering his return to racing after a near career-ending injury as a young horse. The racehorse’s dietary needs are a very important aspect of their success, and McMillan has had a lot of input into producing a feed programme that suits each horse. Sport Horse is also the feed of choice for Simon’s racehorses, as it contains digestible steam-flaked grains including oats (for fast-release energy) as well as cold-pressed canola oil and high levels of organic trace minerals and natural vitamin E.
The Wilsons are also keen hunting and pony club members and are very involved with organising low-level
charity equestrian events. McMillan not only has feed options for pleasure-type horses and ponies but they have been long-term supporters of these grassroots events.
Partnering with one of the few feed companies that use only
New Zealand-grown grains is very important to the Wilsons, who are passionate about the domestic farming industry. The feed is fresh, consistent and cost-effective – but most of all, the horses love it.
The Wilson family are very proud to be associated with McMillan Equine Feeds and look forward to continued joint success in the future.
For more information contact your local Nutrition Specialist.











Crawling insects can infiltrate and occupy living and storage areas, posing health risks as disease carriers as well as causing considerable damage and irritation. The definition of a crawling insect is an insect that does not have wings, though some of the larval (or juvenile growth) stages of flying insects can also cause damage when they are wingless, such as the carpet beetle.
The list of crawling insects in New Zealand that are commonly seen is extensive but the main pest contenders are ants, cockroaches, slaters, fleas, mites and silverfish. While they are not insects, spiders feature prominently too, especially the white-tailed spider. Numbers of infiltrating crawling insects can at times reach plague proportions and controlling them can be a daunting task.
One of the biggest misconceptions about insect control is that all products that state “controls insects” on the label are equal. If maximum control is expected for crawling insects, then the correct product and formulation must be used. All chemicals, no matter which chemical group they occupy, fall into one of two categories: repellent or non-repellent. While the label may state that a particular product will have efficacy over a wide range of both flying and crawling insect pests, this does not mean that it is capable of achieving both long-term control and the high level of knockdown that is required. Crawling insects will not travel over a chemical formulation that is repellent. A small percentage of the insects will be controlled if contact is made during
application but the remainder will steer clear of the sprayed area and will still be active and survive.
For crawling insects, a proven non-repellent insecticide must be used for satisfactory results. This ensures that targeted insects are unaware that their living and crawling space has been treated thus increasing the chance they will come in contact with the treatment, even if they were not in range during application. The use of No Pest Crawling Insect Spray as an inside or outside application will ensure that crawling insects, as well as any flying insects that land on the treated surface, will be controlled for many months. It has both a quick knockdown as well as long-term residual control which makes it an ideal companion product to any baiting programme. Being non-repellent and also non-phytotoxic, No Pest Crawling Insect Spray has been used successfully against mosquitoes. When daytime harbourage areas are treated then alighting mosquitoes quickly die on contact with the treated surface.

Numbers of infiltrating crawling insects can at times reach plague proportions and controlling them can be a daunting task... “
For further information, contact your Farmlands Technical Field Officer or the friendly team at your local Farmlands store.
Article supplied by Key Industries.









With safety at the forefront of all farm activity, there is no better time than now to assess the safety in your shearing shed.
Due to the busy nature of activity undertaken in and around shearing sheds, the opportunity for an accident to happen is high. You can minimise the risk of accidents in your shearing shed by reviewing the current safeguards your shearing machinery offers.
• Does my shearing plant offer safety cut-out in case of lock-up?
• Is my shearing plant isolated from electric shock?
• Does my woolpress have a safety guard?
• Is my woolpress operator safe?
Injuries that are preventable cost farmers, contractors and the wool and shearing industries money. Due to technology advances, shearing machinery now incorporates more safety features than before. The extra cost of an upgrade to a higher quality machine is a small price to pay for superior safety in a busy, high-stress work environment.
Heiniger’s New Zealand National Sales Manager, Kevin Thirkell, articulates what the risks look like in a real-world context.
“Shearers, contractors and farmers increasingly demand tools that provide them with function but do not compromise on safety. For example, in the past when there has been a lockup, the hand piece can spin around at approximately 3,500rpm – making it an incredibly dangerous and life-threatening weapon – leading to the possibility of serious injuries.”
“A safe and light shearing machine, with the advantage of a downtube isolated from all electrified components, reduces any risk of electric shock,” advises Kevin.
The Heiniger Evo Shearing Plant has fast become a market-leader as it was the first shearing plant in the world to be manufactured with an electronic safety switch stopping the machine in case of dangerous handpiece “lock-ups”. It is also extremely light, at only 7.8kg (machine only).
A safe, fast, efficient woolpress is also vital for shearers. Key features to look for when upgrading or checking your machine is:
• Safety: A fully fitted and approved mechanical safety screen and safety device for operator safety.
• Toughness and durability: For intensive use season after season and ensuring expensive servicing is reduced.
• Speed: To ensure high yield and efficiency when pressing bales.
• Ergonomics: Such as a low filling height to avoid stress and strain on an operator’s back.
• Robotics: High-tech machines offer a fully automatic bale ejection system to help your shearing operation.
The TPW Xpress Woolpress is widely used by farmers, shearing contractors and many woolstores where the above requirements are demanded. This machine has long been renowned for its speed and toughness. It has been proven as the fastest press on the market, with a cycle time of

12-16 seconds in high-yielding wools when pressing bales up to 200kg.
Heiniger offers innovative, safer solutions for your shearing shed.
With the Evo Shearing Plant and TPW Xpress Woolpress on the market, there are now few excuses for farmers not to be able to better protect themselves and their staff.
For further information, contact your Farmlands Technical Field Officer or the friendly team at your local Farmlands store.
Article supplied by Heiniger.



















see www.bridgestonetyres.co.nz.









































†For agricultural tyre pricing, please ask in store for details.

























































and

In the first of a series of articles covering the three dimensions of soil, a forage specialist talks about soil’s physical health.
Without healthy soil, we would struggle to feed ourselves. For soil to have a clean bill of health its main elements –the physical (sand, silt, clay particles), the chemical (nitrogen, phosphorus and so on) and the biological all need to be right. These elements are interrelated, so if one’s off it can affect the others.
What makes a physically healthy soil?
Aerated structure is a very important aspect of soil’s physical health. A healthy soil is 25 percent air, 25 percent water and about 8 to 15 percent living and dead organic matter. The remaining 35 to 42 percent is a mix of silt, clay and sand, in varying proportions depending on the parent material from which the soil formed. This mix gives the soil its texture and structure.
Structure affects the pore space in the soil, which in turn influences root growth and air and water movement. Soil particles and organic matter over time arrange into small clumps (peds) which give the soil structure. The shape of the clumps depends on the composition but also the conditions, like wet and dry, freezing and thawing, foot traffic and farming or cultivation techniques. Shapes include granular (like gardening soil), single-grained (like beach sand) and massive (like modelling clay). Knowing the texture of your soil helps you manage it and maintain its health. Texture comes from the relative percentages of sand, silt, and clay. Soil falls into one of 12 textural classes of soil, ranging from clay at one end to sand at the other.

Although soil colour is influenced by its mineralogy, it can also reveal levels of organic matter. Soils high in organic matter are dark brown or black. Well-drained soil is brightly coloured whereas soil that is often wet and soggy has a mottled pattern of greys, reds and yellows.
What can be done to maintain the physical health of soil?
What we are doing to our soils is exactly what the Greeks, Romans and Sumerians did to their soil – overworking them through cultivation and not valuing the organic matter lost during cultivation. This slowly turns the soil into a desert. Cultivation exposes the soil to loss via wind and water erosion and organic matter loss due to mineralisation.
To maintain a healthy soil, it is important to:
1. Leave it undisturbed (not cultivated).
2. Keep it covered with vegetation.
3. Grow a variety of species (different species exude different carbohydrates from roots to feed a greater variety of soil microbes).
4. Maintain a moderate-tohigh soil fertility. The more vegetation grown the more food there is for soil microbes.
For further information, contact your Farmlands Technical Field Officer or the friendly team at your local Farmlands store.
Article supplied by Ballance Agri-Nutrients Forage Specialist Murray Lane.








Forage brassica crops attract the same insect pests every season. In the past, to impact these pests when applying an insecticide by air there have only been the options of broadspectrum insecticides, that kill both the pest and important beneficial species, or selective products with a limited pest spectrum.
Following the aerial approval for selective insecticide Exirel® from the agricultural sciences company, FMC New Zealand, a wider spectrum of pests can be impacted via helicopter, while adopting an integrated pest management (IPM) approach to pest control.
The Farmlands field team have been keen to adopt the use of IPM to control insect pests in their clients’ forage brassica crops. The methods of control within an IPM approach fit into three categories: biological, cultural and selective chemistry.
The Technical Field Officers (TFOs) have participated in field training and actively assess crops, identifying the beneficial insect species – the biological control, as well as the pest species present before using any chemistry.
Eric King, Technical Field Officer based at the Farmlands Mossburn store, says IPM gives the farmer clarity.
“Farmers tend to be stand offish on the use of insecticides. Now we can go into a crop and identify the good bugs,
show the farmer what we want to keep and what we need to take out,” he says.
“Clarifying the difference between good and bad bugs and having a good plan gives them more confidence in the right way to use an insecticide. Once they know what to look for, Farmers like to see the beneficial bugs working in the crop and will make sure they look after them.”
Exirel® is a translaminar product that must be ingested, meaning it sits in the layers of the leaf and impacts the pest only when they try to feed on the crop. Exirel® remains in the leaf for some time, impacting not only the target pest but also other pest species as they try to establish in the crop after spray application. During this time the beneficial species also establish in the crop, providing another layer of control against the pests. Thanks to the selective chemistry of Exirel®, those ‘good’ bugs will not be negatively impacted by the application.
Until recently, Exirel® has only been available via ground application.
“Having aerial approval is going to be brilliant. It will open up the gate for clients who could only use harsher products due to accessibility or wanting to avoid crop damage,” Eric says.
For further information, contact your Farmlands Technical Field Officer or the friendly team at your local Farmlands store.
Article supplied by FMC New Zealand.
















The adoption of selective insecticides is gaining pace in forage brassica crops, as farmers move away from using broadspectrum organophosphate-based sprays. Farmlands Assistant Sales Manager for Eastern Otago, Kieran Fowler, explains why he recommends certain products to his clients for use after Christmas.
“I’m not a fan of using harsh organophosphate chemicals and using a selective insecticide is better for everyone,” Kieran says.
“If you can save a second spray because you have beneficial insects working for you, that product’s worth its weight in gold.”
Minecto Star contains a full rate of cyantraniliprole, plus pymetrozine which is a systemic insecticide with strong activity against aphids. Minecto Star is approved for the control of a wide range of insect pests in forage brassicas including: grey cabbage aphid, diamondback moth, white butterfly caterpillar, leafminer and nysius.
The main modes of action cause a rapid cessation of feeding and paralysis, followed by starvation. Aphids may still be seen on leaves for up to five days after application but they are no longer feeding or causing damage to the crop. “We’re getting three to four weeks’ control from Minecto Star compared to only about five days with common organophosphate pesticides,” Kieran says.
Minecto Star can replace the use of organophosphate-based insecticides in most situations except for springtail and nysius control early in the season, where they remain an important management tool.
Beneficial insect populations are relatively low early in the season, so organophosphates can be applied early (pre-Christmas) with minimal disruption to beneficial insects.
The best time to apply Minecto Star is when caterpillars and aphids are starting to build in population, generally in the mid-to-late part of the season as temperatures rise after Christmas. This timing also coincides with higher numbers of beneficial insects such as ladybirds, hoverflies, parasitic wasps and lacewings which establish if there are hosts or prey present to eat or parasitise. A maximum of three sprays of Minecto Star (or other Group 28 insecticides) can be made per season with no more than two consecutive applications.
According to Kieran, most farmers now understand the importance of maintaining beneficials in their crops. “If you use chlorpyrifos for aphid control you can have an even bigger aphid population two weeks later but with Minecto Star it’s still working with the help of beneficials. It’s also stronger on aphids than some products, because pymetrozine is systemic which assists with coverage and provides longerlasting aphid control.”

...you can save a second spray because you have beneficial insects working for you...” “
“I will be recommending the product again this season post-Christmas, because it’s got the job done and has kept forage crops looking very clean. I’ve been surprised by the amount of beneficials I’ve seen in crops since using Minecto Star, with more hoverflies and ladybirds in particular. The product will do a better job than organophosphates so it’s great for everyone involved, including spray contractors who don’t like spraying organophosphates.”
For further information, contact your Farmlands Technical Field Officer or the friendly team at your local Farmlands store.
Article supplied by Syngenta.
NZ’S MOST VALUABLE CARD? YOU DECIDE.


There’s a heap of travelling to be done between now and the end of summer, so make sure you fuel up and save 12 cents per litre* with your Farmlands Card at any Challenge, Z and Caltex service station.

Seasonal conditions notwithstanding, a systemic, efficient harvest of apples and summerfruit in the weeks ahead hinges on the ability to optimise one critical resource that remains in short supply – namely, the orchard workforce.
Some aspects of labour management are beyond grower control despite industry efforts to increase the pool of available workers, in line with the continued expansion of planting.
Manipulating crop maturity however, can be directly influenced inside the orchard gate and with careful preparation and execution, helps optimise harvest management without compromising fruit quality.
ReTain® plant growth regulator has several physiological benefits for apples and summerfruit (apricots, peaches, nectarines and plums) and acts as a tool to maintain a consistent flow of work for pickers and post-harvest staff.
Nufarm Technical Specialist
Cynthia Christie says utilising ReTain to its full potential starts now, particularly for summerfruit.
“The timeframe can be quite tight if summerfruit growers have not already planned ahead – applications are typically made 14 days pre-harvest and that occurs before Christmas for the earliest local market cultivars,” she says.
“It’s definitely worth investigating if the schedule is feasible. In apricots, plums, nectarines and peaches, the maturity delay is shorter than in apples (2–3 days), which is enough to make a significant difference in fruit firmness.
“Treated fruit has fewer defects; the crop tends to handle better and maturity is more consistent. There is also a potentially significant yield advantage in some varieties, because ReTain lessens the risk of fruit drop,” advises Cynthia.
Apple growers have a longer lead time to review harvest dates for

different blocks and varieties (21–28 days for varieties other than Braeburn and Cox’s Orange Pippin, which are 14–21 days) and are becoming increasingly focused on precise scheduling to capture the full benefit of extending harvest by 7–10 days.
Cynthia says there are several factors to take into account before applying on apples.
“Historical harvest dates can be helpful in deciding when to treat different blocks. We also recommend closely tracking current growth conditions and temperatures because ReTain must be used with Freeway organosilicone adjuvant to perform properly and applying this to hot fruit should be avoided,” she says.
Growers also need to allow for a minimum 7-day interval between calcium sprays and applying ReTain. The plant growth regulator should not be applied if calcium residues are present.
How the product is applied can be just as important as when, Cynthia says.
“Applications should be made when drying conditions are slower, such as in the early to mid-morning period in order to ensure adequate absorption. On orchards which use foil mulch or reflective films, ReTain should be applied before laying these down.”
For further information, contact your Farmlands Technical Field Officer or the friendly team at your local Farmlands store.
® ReTain is a registered trademark of Valent BioSciences Corporation.
Article supplied by Nufarm.







Adequate amounts of water are needed to maintain good levels of production and stock health. Limiting water intake reduces animal performance quicker and more drastically that any other nutrient deficiency.
Understanding your stock’s optimal water requirements, the components that make up a reticulated water system and where to go for advice are key to developing, upgrading or maintaining an efficient stock water system.
System components include:
• Intake: Powered by gravity or mechanical/electric means
• Storage: Tanks, dams
• Reticulation: Pipes and fittings
• Outlet: Troughs, trough valves
Ensuring adequate water is consistently available to meet your stock’s daily water requirements is essential. As animals do not drink evenly over a 24-hour period, storage typically needs to be built into systems to cope with peak demand. Likewise, pipe diameters need to be able to handle this greater water volume or the reticulation network becomes a system bottleneck, preventing adequate supply to the troughs.
System water intake is determined by the water source location and topography of the farm. Systems vary from a complete gravity system to a complete pumped pressure system. A pumped gravity option pumps water up the hill with a pressure main and back down from storage tanks with a gravity main.

The size, shape and number of troughs per paddock are an outcome of the type of stock and their numbers.
Stock type also decides trough size and height. Best shape is used to suit location, for example oblong troughs can be used through a fence line to provide water to two paddocks and around one enables the best stock access in the middle of a paddock.
Diameter is determined by the required number of stock needed to access a trough at any one time, which also influences the decision as to number of troughs per paddock.
Water storage should not determine trough size as at the end of the day, it is a drinking vessel so the delivery of adequate, fresh, clean water is an outcome of a correctly designed reticulation system. Trough valve selection is governed by the pressure and flow requirements, which are also outcomes of the reticulation design. While the calculation of water requirements, pipe diameter and
pressure class is a reasonably easy process to work through, what requires more time and specific technology is the property survey. It can take years of experience to plan and deliver the optimal reticulation network layout. Farmlands has made it easier to source this sort of professional advice. Simply fill in your contact details on Farmlands’ Water Management web page to receive a free on-farm consultation. Make sure to tick the box agreeing to share information with Iplex Pipelines and you will be contacted to talk through your stock water requirements. Your stock water reticulation system is too valuable an asset and productivity tool to second guess what will and will not work.
For further information, contact your Farmlands Technical Field Officer or the friendly team at your local Farmlands store. www.farmlands.co.nz/stockwater Article supplied by Iplex Pipelines.


























































































































Contact us today to update your festive season fuel requirements to keep you moving.




North Auckland/Northland
Paul Topper 027 558 3308
South Auckland/Waikato
Eddie Powell 027 530 3008
Taranaki/Wanganui
Grant Stachurski 027 774 4446
Nelson/Blenheim/West Coast
Phil Gavin 027 279 4020
Bay of Plenty/Coromandel
Nigel McFadyen 027 603 0519
East Coast/Hawke’s Bay
Grant Miller 021 246 1010


For more information call us on 0800 666 626 or email fuelaccountmanagement@farmlands.co.nz
Wellington/Wairarapa/Manawatu
Darryl Watson 027 545 4563
Canterbury
Nathan Winter 027 644 4435
South Canterbury/North Otago
Garry Ballantyne 027 279 2008
Central Otago/Otago
Mike Casey 027 479 4342
Southland
Scott Ayto 027 705 5931





For 60 years Bell-Booth has been a family-owned agricultural company that manufactures and distributes quality products that New Zealand’s farmers rely on. Since our inception in 1960 Bell-Booth has continued to be agile and forward thinking. Founder Rex Bell-Booth was the first person to import seaweed extract from the cold waters off Norway. This was something quite unique for the time. Fast forward 60 years, and seaweed is widely used by horticulturalists, gardeners and pastoral farmers as a biostimulant.
The company has continued to evolve under the ownership of Stephen, Julie and Ben Bell-Booth. A manufacturer, exporter and importer, Bell-Booth Ltd is a multi-dimension provider to the rural sector. Our product range spans from environmental care to animal health products.
Pestoff® is a pest control range of NZ-made rodenticide and possum bait and a full range of stations and traps so farmers can carefully administer the product to the target pests.
IntenSE® is a range of liquid and powdered mineral products. New Zealand’s soils are deficient in trace elements, so we tailor our nutritional programmes to the profile of each farm. This helps cows manage metabolic changes and the challenges of calving and mating.
Bell-Booth’s Dosatron® is a kiwi icon – most New Zealand dairy farmers own one. The Dosatron system offers farmers a brilliant solution to adding water-soluble products like zinc, magnesium, selenium and copper to water troughs in order to sustain and improve cow health and production. Introduction of Dosatron to the New Zealand market in 1989 was an industry-transformational moment – it removed the need for daily drenching by enabling minerals and trace elements to be precisely offered to livestock via the waterline.
Nutrimol® is another New Zealand icon. Nutrimol® is a seaweed-based mineral supplement that enhances fertility in dairy cows. To date, over 700 million doses have been offered to New Zealand dairy cattle.
Queen of Calves® is a natural, powdered product made from plant extracts. It enhances the type and rate of early growth in calves. Farmers add Queen of Calves to milk and feed it to their herd replacements during the milk-feeding phase. The calves grow about one kilogram faster each week during the early period compared to a calf raised on a conventional milk and meal diet. The treated animals become more productive cows as adults.
Bell-Booth Robotic Feeders represents the world-famous Holm & Laue range. Each Holm & Laue unit enables up to 150 calves being fed their precisely-allocated volume of warm milk. Our robotic feeders are helping New Zealand farmers to grow better herdreplacements and get their lives back!
While our Head Office and production is based in the Manawatu, Bell-Booth is proudly represented by a team of experienced Product Specialists who cover the rural heartland of New Zealand. With great people and great products, we look forward to supporting the rural sector for another 60 years.

































































































































































































The New Zealand Century Farm and Station Awards aim to capture and preserve the history of our country’s farming families. Each month we will share stories from Farmlands shareholders who have worked their land for 100 years or more.
After hearing of the farming opportunities in Southland, John Thomson and seven of his children set sail from Kinross, Scotland, in 1864 to join his two eldest sons in New Zealand. After four years of work contracting with a team of bullocks throughout the Southland District – fencing, carting gravel for roading and other goods –with the help of his family, John was able to purchase his first land near Winton on the banks of the Oreti River. This flat Southland alluvial flood plain, which was covered in scrub and flax in places, soon proved to be a good choice for him. He set up a flax mill and farmed sheep, beef and grain. By the early 1890s, the family had extended their first 2,000 acres to 4,000 and was sending wheat under

contract to Sydney. In one year, John had a contract payment in excess of £1,000 more than he had expected. Over the years, this land was settled by family and extended family and some was sold off to others. His eldest son, Peter married Julia Henderson and together they farmed about 900 acres with their five sons and two daughters, two of whom went to WW1. David died of the measles and William returned home to what was now called

Thomson’s Crossing, alongside his three brothers, John, Peter(II) and Walter, who also had farms of their own.
In the early 1950s one of John’s great grandsons, Peter(III) took over 346 acres of William’s land and later bought 80 acres off the Education Board. In 1977 he took his son, Peter(IV) into partnership and together bought 140 acres in 1984 – a further 60 acres was added in 1987.
With the sudden death of his father in 1993, Peter(IV) took over the farm in partnership with his wife, Norah and with family help has extended the farm to 1,000 acres of which almost 900 was owned by John or his son, Peter. In 2018 the farm Springburn in its 150th year, saw two of their sons, Peter(V) and David join the partnership to be the sixth generation farming at Thomson’s Crossing – adding calf rearing and selling of Jersey bulls for breeding to the sheep and lamb business.

































It started with a dream 30 years ago. The possibility of living off the grid, harvesting their own power, heat, water and food appealed to experienced tradesman Mac and health-coach Marina. Three decades on and they have created the ultimate eco-friendly superhome.
Situated between Christchurch and Dunedin, just minutes away from the township of St Andrews, sits Shiloh Eco Farm. Completed in 2015 with magnificent views of the Southern Alps, this is the third off-grid superhome designed by Mac and Marina Mackintosh. It was inspired by the Kiwi ingenuity that built the Benmore Hydro Dam in the 1960s, a scheme that supplied near-free electricity to New Zealand (before it was privatised).
For Mac and Marina, this build was about independence and reclaiming their freedom from the “rat-race”.
“We have always been united and proactive in healthy, off-grid country living and inspiring others to do the same,” Mac says.
Developed with simplistic ease in mind, Shiloh Eco Farm is a hub for visitors from far and wide. Mac and Marina keep their doors open to provide guidance on the features of a superhome and better usage of natural resources.
“Even the local builders, plumbers and electricians learnt a lot of new ecological building practices when they built our house,” Mac says.
As well as an eco-garden, the couple have set up a purpose-built animal hotel. Guests have included chickens, goats and Wiltshire sheep. The chickens are given free range across the 4ha property, which Mac says helps to control parasites and spread phosphate.

The practical property has also acted as a base for a variety of business ventures including engineering, counselling, a Bed and Breakfast and an international logistics operation.
With Mac and Marina moving on to travel and speak about sustainable living and suicide prevention, before beginning the build on a fourth superhome closer to their family, a wonderful opportunity has opened up for a new owner.
Structural and sustainable credentials for sale
Shiloh Eco Farm was created with a vision of closed-circuit sustainability. Power is supplied through solar panels, a recyclable battery bank and back-up generator. With no power bills to worry about, the lights only go out when farm residents want to gaze up at the Milky Way on a clear night.
The structure of the homestead is engineered genius. Built by local builders, Dimension Building, Shiloh exceeds New Zealand building standards and is practical, durable and stylish. The hip roof provides structural strength and extended eaves offer
supreme weather protection and a drier, warmer home.
Internally, award-winning Earthwool glasswool insulation wraps around high-quality Oregon framing. The latest homeware technology flows to the cold-room, a feat of natural airflow engineering. With no power required, this room keeps food and drinks cool.
All sewerage and wastewater is processed without chemicals on-site, using tiger worms to break down waste.
The treated water is fed out to willow trees, which in turn are fed to the stock, all with very little maintenance involved.
“We have helped educate lots of people on how to duplicate what we have done,” notes Mac.
“But some people would prefer to simply walk into a ready-made, sustainable superhome. We have provided that here.”
If you are ready to follow your own dream – take a leaf out of the Mackintosh’s eco-book and check out this stylish superhome that is currently for sale. Please contact Adam Rivett on 0274 288 143.









Rural property markets are adjusting to tough new realities in New Zealand’s approach to environmental management and shifts in the agri-banking sector regulation. Such adjustment isn’t easy, but, of course, it’s hardly without precedent.
Firstly, in September, the plan to protect and improve freshwater quality was rolled-out. Farms now require land and environment plans. New nitrogen loss limits will curb production potential from some land uses in some areas, adding complexity and cost relative to traditional dairying and livestock farming practices.
Diversification has long been synonymous with New Zealand’s primary sector. Here’s
another set of reasons for looking at new crops and new categories of livestock, primarily where consumers will provide additional rewards to the producer for their environmental stewardship.
Integrated farming systems are more likely to present in the future. It’s worthwhile acknowledging that the nation’s best practice farmers and growers are often already “there” on this new reality.
Second, surging rural debt levels. The Reserve Bank puts the total now at $62 billion. A 15-fold increase from around $4 billion in 1990, reflecting massive investment in building the productive capacity of land-based industries for the good of this nation.
Dairying, the stand-out in terms of growth in NZ export receipts, accounts for twothirds of total rural debt. The Reserve Bank has moved to tighten capital requirements on commercial banks operating in
New Zealand, limiting their capacity to fund domestic lending.
The property market will see banks tightening lending criteria, sharpening the way business cases behind individual farm purchases or expansions are examined, focusing more on principal repayment schedules. Bank borrowing, land and productive assets will get valued far more for their future earnings, and less on expectations of capital gain.
In the latest year to June, $17.6 billion of dairy receipts were 39% of the nation’s total primary sector export income. We’re a growing share of global dairy trade.
A long-standing dairy investor noted the other day, “Our business has never worked to industry averages as our success benchmark or reason to invest”.
Conrad Wilkshire, GM Rural for Property Brokers Ltd



An incomparable masterpiece, this superbly executed private luxury estate impresses from the moment you enter through the electric gates and down the sealed driveway to this majestic property.
Some of the many features include:
• Six bedrooms
• Four Living
• Eight car garaging
• Fully fenced and sheltered into six paddocks with Deer complex
Occupying a premium site an easy 30 minute drive to the heart of the vibrant CBD and moments to the local village with its shops, restaurants and businesses as well as popular Kirwee School, estates of this size and distinction are rare. Endless opportunity for functions, extended family or guests.
For Sale By Negotiation View By appointment
Tracy Stevenson M 027 543 9029 P 0800 367 5263
tracys@pb.co.nz



21 1 1
After 100 years this property is now reluctantly for sale. Located 12 km south of Dargaville just off State Highway 12, this 78 hectare property is currently leased to the neighbouring dairy farm for an annual lease of $38,000 pa until June 2020. Fenced into approximately 22 paddocks, water is supplied from a large dam. There is also a limestone quarry. Contour is best described as a mix of some 28 hectares flat to rolling land and the balance steeper hill. Buildings comprise of a small two storied dwelling, an old cowshed, storage shed with a lean-to, tractor or car shed. Many options await the new owners to improve this property and ready to stamp their own mark, be it fattening stock or rearing calves – the choice is yours.
Viewing is strictly by appointment only with the Vendors Agent.
Tender closes 3.00pm Thursday 12 December 2019 (unless sold by private treaty).
View By appointment
Tom Hackett
M 027 498 2908
P 0800 367 5263
tom.hackett@pb.co.nz

12.1405 hectare superbly located alongside SH1 in the renowned berry fruit-growing areas of Waimate. Architecturally designed, licensed café and retail shop selling produce from the farm. Potential to add further crops. Consent to take up to 15 l/sec to irrigate the whole property.
Here is an opportunity to grow this well-established business.
Waharoa Wairere Road

Outstanding road frontage to State Highway 27 with access off Wairere Road. Subdivision scheme plan is in place to create three lots being 1.52 hectares, 1.00 hectare and 2.93 hectares.
An ideal high-profile site with an ability to add immediate value.


For Sale By Negotiation View By Appointment
Tim Meehan M 027 222 9983 tim.meehan@pb.co.nz
Ian Moore M 027 539 8152 ian.moore@pb.co.nz


For Sale $840,000.00 + GST if any View By Appointment
Ian Morgan M 027 492 5878 ian.morgan@pb.co.nz



















































































































